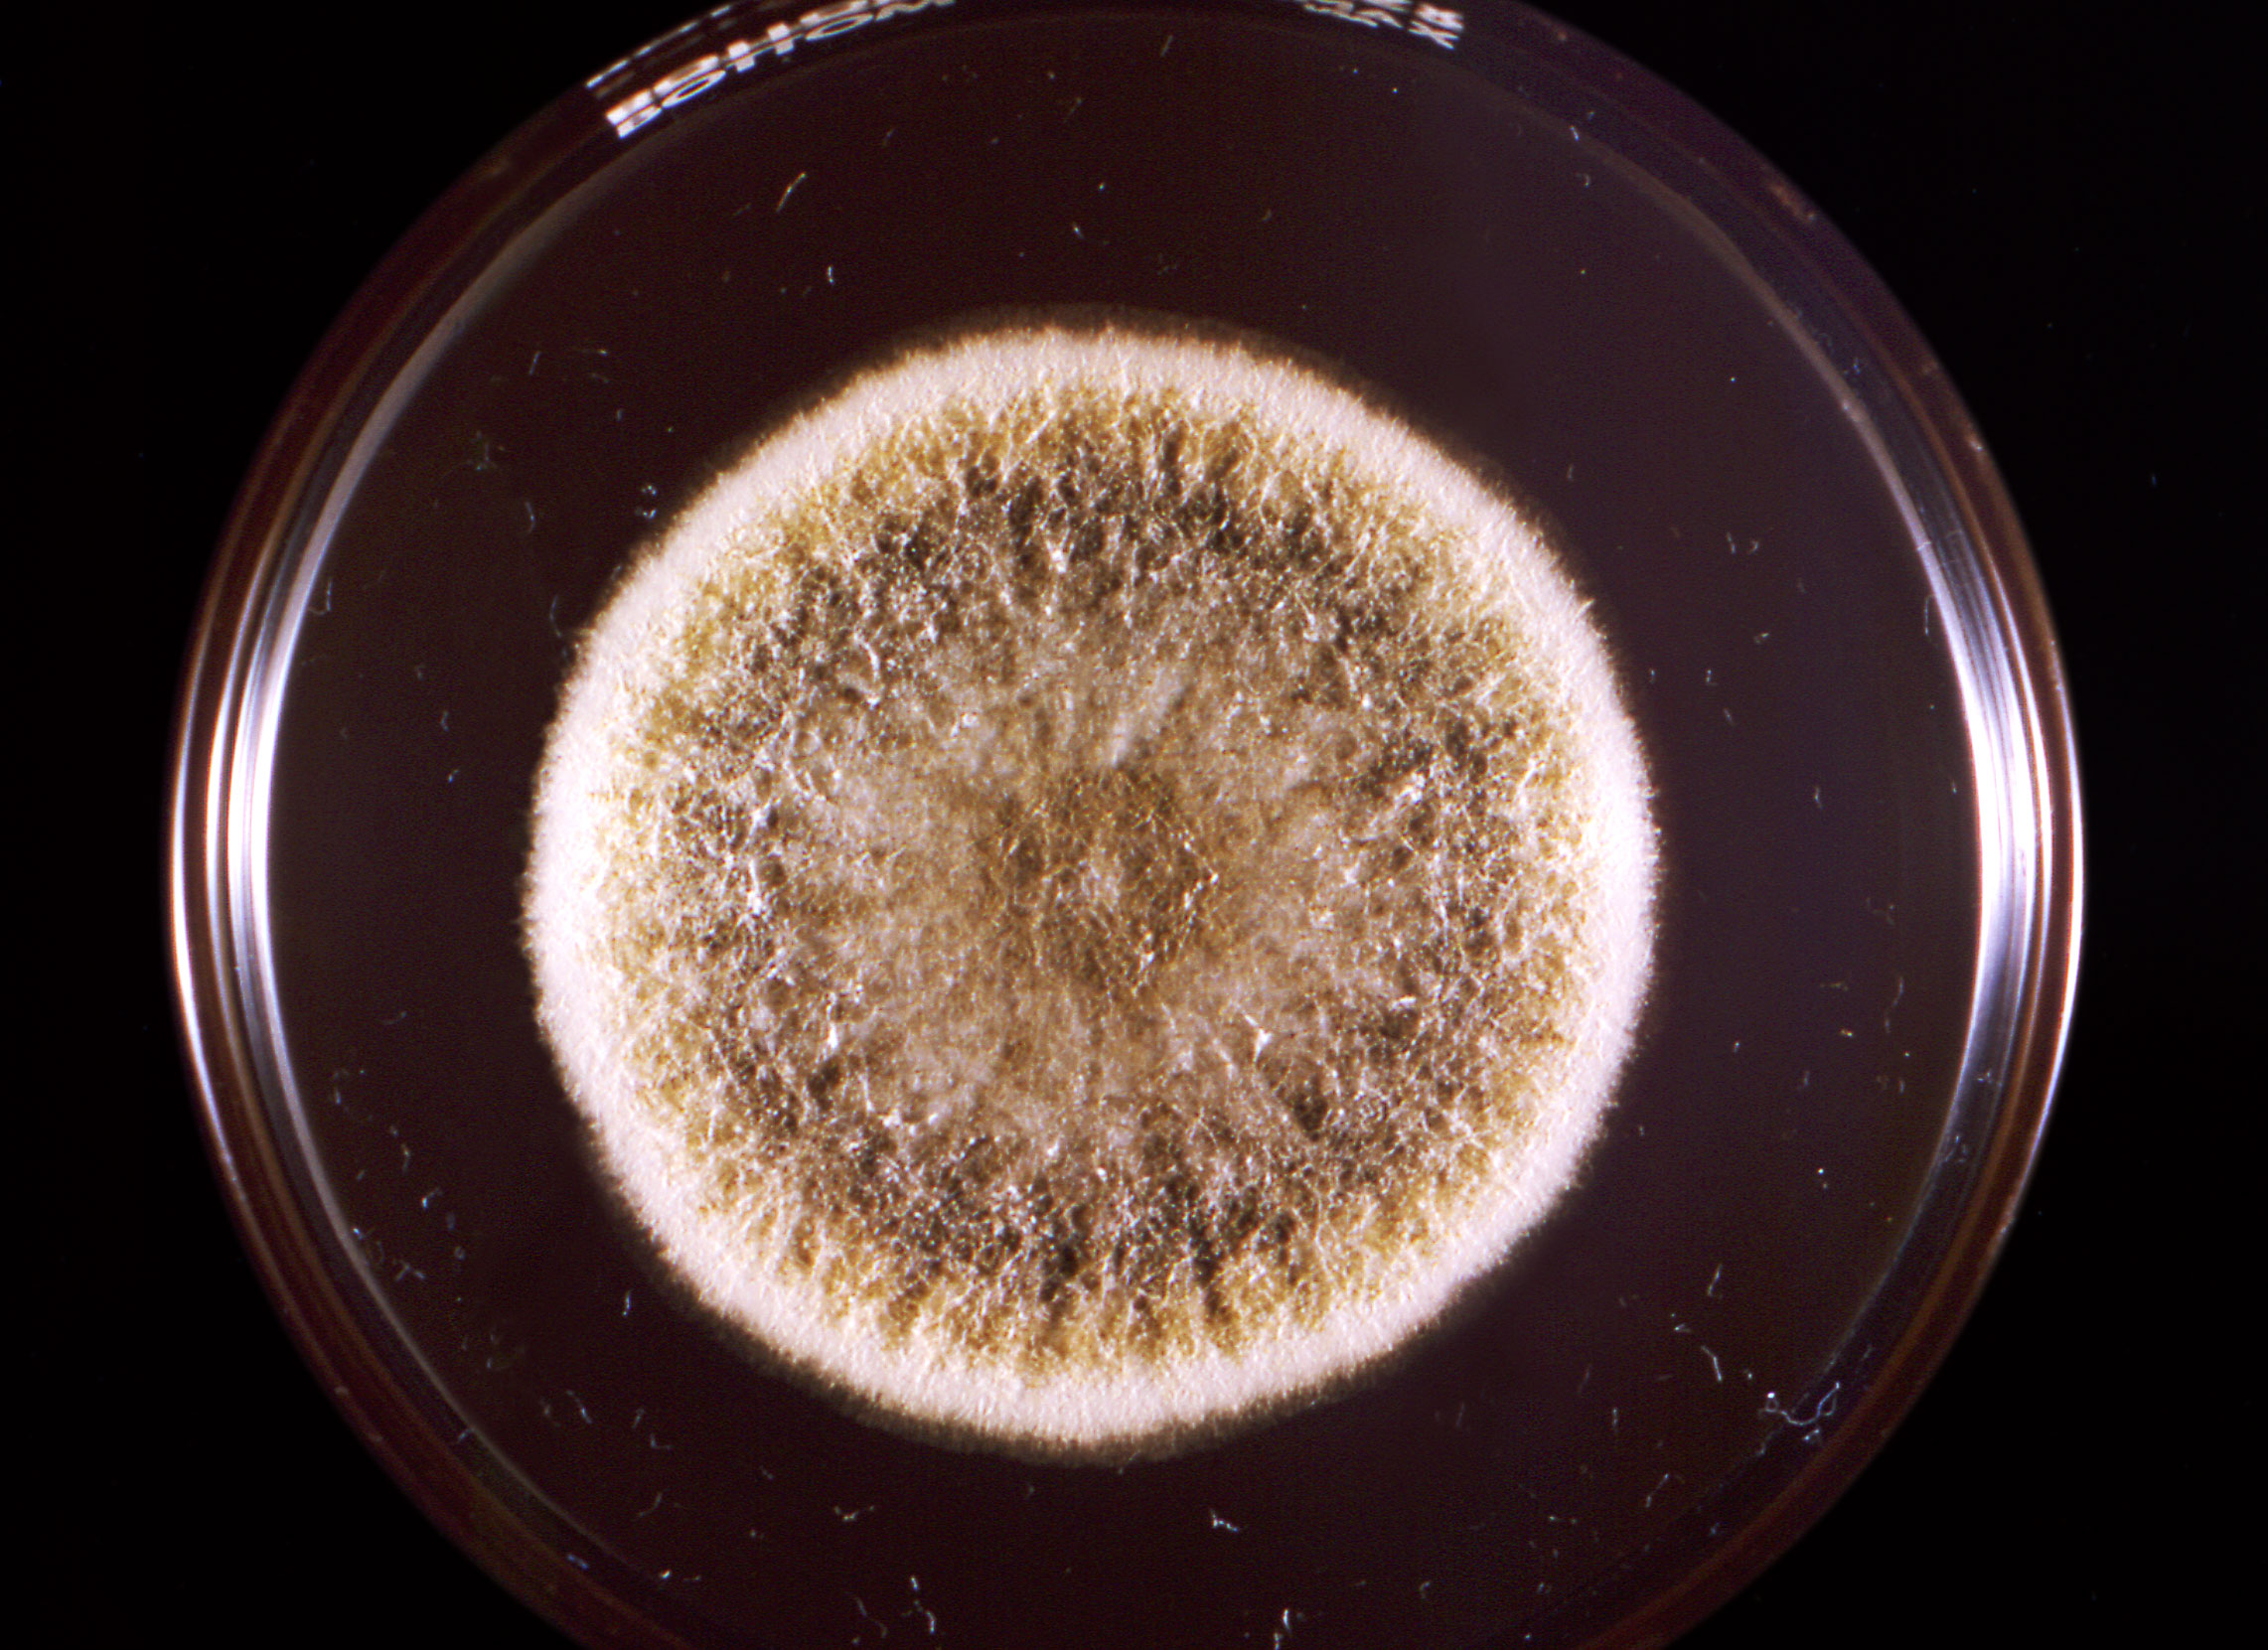

Epidemie
Un altro focolaio di rara epidemia fungina: colpite oltre 90 persone
Diciannove casi confermati di blastomicosi, un tipo di infezione fungina, sono stati collegati a una cartiera del Michigan settentrionale, con altre 74 persone ritenute casi probabili, secondo le autorità sanitarie locali.
I funzionari della sanità pubblica hanno dichiarato il 7 aprile che sia i casi confermati che quelli probabili sono lavoratori della cartiera Escanaba Billerud infettati dalla blastomicosi dopo averne mostrato i sintomi. Un caso si definisce «probabile» è una persona con sintomi con un test antigenico o anticorpale positivo.
La blastomicosi è un’infezione causata da un fungo chiamato blastomyces che vive nel suolo e nel legno in decomposizione.
In precedenza, il 28 febbraio, la Public Health Delta and Menominee Counties (PHDM) è stata allertata per la prima volta di diverse infezioni da polmonite atipica in individui impiegati presso lo stabilimento, riporta Epoch Times.
Il 3 marzo, la cartiera ha appreso delle infezioni dal PHDM. La fonte esatta del fungo non è stata ancora trovata. Tuttavia, si ritiene che sia arrivato all’azienda su legno umido e marcio.
Gli esperti hanno affermato che un focolaio che colpisce un gran numero di persone è molto insolito in quanto la malattia fungina di solito non viene trasmessa da persona a persona.
Ai lavoratori del mulino viene ora chiesto di indossare maschere N95 fornite dall’azienda. È in corso la pulizia approfondita dei sistemi di ventilazione nello stabilimento, come consigliato dai funzionari sanitari, per evitare la diffusione della malattia.
Secondo i Centri statunitensi per il Controllo e la Prevenzione delle Malattie (CDC), il fungo Blastomyces vive nel terreno umido e nella materia in decomposizione.
Le persone possono contrarre la blastomicosi dopo aver respirato spore fungine dall’aria, che possono infettare i polmoni.
La maggior parte delle persone che respirano le spore non si ammala, ma alcuni potrebbero manifestare i seguenti sintomi: tosse, febbre, dolore toracico, difficoltà respiratorie, sudorazione notturna, affaticamento, perdita di peso, dolori muscolari e dolori articolari.
Nei casi più gravi, il fungo si diffonde dai polmoni ad altri organi, inclusi muscoli, ossa e cervello. Possono essere necessarie da tre settimane a tre mesi prima che i sintomi compaiano dopo l’esposizione al fungo, afferma il CDC.
Come riportato da Renovatio 21, tre settimane fa il CDC aveva lanciato un allarme per la rara malattia fungina della Candida Auris, un fungo emergente sempre più farmaco-resistente che rappresenterebbe una «grave minaccia per la salute globale».
Due settimane fa si è avuto in India il primo caso noto di un essere umano infettato da un fungo vegetale che di solito si trova sugli alberi, il Chondrostereum purpureum.
Epidemie
La Russia sottoporrà a test per l’epatite tutti i lavoratori immigrati. E l’Italia?

A partire da marzo 2026, la Russia imporrà ai lavoratori migranti di sottoporsi a test per l’epatite B e C, ampliando le attuali disposizioni di screening medico. Le nuove regole si applicheranno ai cittadini stranieri e agli apolidi che entrano in Russia per lavoro, oltre a coloro che richiedono lo status di rifugiato o asilo temporaneo.
Le visite mediche sono obbligatorie per i migranti: senza di esse, non è possibile ottenere permessi di lavoro, residenza temporanea o permanente. I lavoratori migranti devono completare gli esami entro 30 giorni dall’arrivo, mentre chi non intende lavorare ha 90 giorni di tempo. Attualmente, gli screening includono test per droghe e malattie gravi come HIV, tubercolosi, sifilide e lebbra.
Le modifiche al processo di controllo sanitario per gli stranieri in visita sono state proposte all’inizio dell’anno da un gruppo di lavoro sulle politiche migratorie, guidato dalla vicepresidente della Duma di Stato, Irina Yarovaya. La vicepresidente ha chiarito che l’obiettivo è rafforzare il monitoraggio sanitario degli stranieri in arrivo e prevenire la diffusione di malattie pericolose.
I lavoratori migranti sono fondamentali per l’economia russa, occupando ruoli chiave in settori come edilizia, agricoltura e servizi. Milioni di migranti, soprattutto dall’Asia centrale, sono attratti da salari più alti rispetto ai loro paesi d’origine. Tuttavia, questo afflusso ha sollevato dibattiti su salute pubblica e stabilità sociale. Per questo, le autorità russe hanno introdotto rigidi controlli sanitari e requisiti per i migranti, cercando di bilanciare i benefici economici con la sicurezza sanitaria.
Nell’ultimo anno, la Russia ha anche intensificato la lotta contro l’immigrazione illegale. Il presidente Vladimir Putin ha firmato un decreto che istituisce una nuova agenzia statale all’interno del Ministero dell’Interno, incaricata di migliorare la gestione dei flussi migratori.
Iscriviti al canale Telegram
Il Cremlino ha dichiarato che l’iniziativa punta a razionalizzare il processo migratorio, promuovere il rispetto delle leggi russe tra i migranti e ridurre le attività illegali.
In Italia la situazione epidemiologica dell’immigrazione è un grande tabù del discorso pubblico.
«In base ai dati epidemiologici in nostro possesso, risulta che in Italia il 34,3% delle persone diagnosticate come HIV positive è di nazionalità straniera» diceva in un’intervista a Renovatio 21 il dottor Paolo Gulisano sette anni fa. «Considerato che gli stranieri rappresentano circa il 10% della popolazione italiana, questo dato vuole dire che la diffusione dell’HIV tra gli stranieri è oltre il triplo che negli italiani».
«Un dato che fa pensare. Molti immigrati provengono da Paesi dove la diffusione dell’HIV, così come quella della TBC, è molto più alta che in Europa. Basta far parlare i dati. Il numero dei decessi correlati all’AIDS nel 2016 per grandi aree è il seguente: Africa Sud-Orientale: 420 mila; Africa Centro-Orientale: 310 mila; Nord Africa e Medio Oriente: 11 mila; America Latina: 36 mila, più il dato dei soli Caraibi che è di 9400. Europa dell’Est e Asia centrale: 40 mila; Europa Occidentale e Nord America: 18 mila; Asia e Pacifico: 170 mila. Ora, la lettura di questi numeri ci fornisce delle evidenze molto chiare».
«È quindi chiaro quali siano i rischi di una immigrazione di massa, incontrollata anche dal punto di vista sanitario, e i rischi legati al fatto che un numero impressionante di immigrate africane viene gettato nel calderone infernale della prostituzione, che diventa veicolo di diffusione di malattie veneree».
Iscriviti alla Newslettera di Renovatio 21
Epidemie
Paura e profitto, dall’AIDS al COVID

Iscriviti alla Newslettera di Renovatio 21
Le opinioni dissenzienti sull’AIDS «abilmente represse per decenni»
Shenton era una reporter della BBC, l’emittente pubblica nazionale del Regno Unito, quando sviluppò il lupus indotto da farmaci, dopo essere stata sottoposta a un’eccessiva terapia farmacologica in Spagna negli anni ’70. «Mi hanno dato tutto quello che c’era scritto nel libro», ha detto Shenton. «Certo, sono imploso e mi sono sentito gravemente male. Sono stato al Westminster Hospital per due mesi. Sono quasi morto». L’esperienza ha suscitato in lei l’interesse per le indagini sulle lesioni causate dai trattamenti medici. In seguito è entrata a far parte dell’emittente nazionale britannica Channel 4, producendo una serie di documentari, Kill or Cure. La serie si concentrava sulla riluttanza delle grandi aziende farmaceutiche a ritirare trattamenti pericolosi o inefficaci. «Quello mi ha davvero dato la carica», ha detto Shenton. Nei primi anni ’80, Shenton e il suo produttore vennero a conoscenza della ricerca del dottor Peter Duesberg, un biologo molecolare tedesco che sosteneva che l’HIV non causava l’AIDS. Iniziò a mettere in discussione le narrazioni dominanti. «Abbiamo continuato a realizzare 13 documentari sull’AIDS», ha detto Shenton. Il documentario Positively False si concentra sulla «manipolazione delle aziende farmaceutiche e delle organizzazioni [mediche] interessate in tutto il mondo, che manipolano il terrore della peste», ha affermato Shenton. Il film rivela «la scienza imperfetta che circonda l’AIDS e le conseguenze di seguire ipotesi sbagliate», ha affermato Shenton nell’introduzione. Tra queste, la convinzione che l’AIDS sia infettivo, che sia causato dall’HIV e che l’HIV sia contagioso. «Molti scienziati e ricercatori non sono d’accordo. Queste opinioni sono state abilmente represse per decenni dall’ortodossia scientifica prevalente e dai media mainstream», ha affermato Shenton nel documentario. I ricercatori che mettevano in discussione la narrazione dominante sull’HIV/AIDS sono stati repressi e messi a tacere, così come gli scienziati che mettevano in discussione la narrazione prevalente sul COVID-19, ha affermato Shenton.Sostieni Renovatio 21
Test PCR «completamente inutili» per AIDS e COVID
In entrambi i focolai, sono stati utilizzati test PCR per determinare l’infezione, ha affermato. «Il test [PCR] è completamente e totalmente inutile», ha detto Shenton. I test non possono «distinguere tra particelle infettive e non infettive». Shenton ha affermato che i diversi Paesi utilizzano standard diversi per determinare una diagnosi positiva di HIV. «Si potrebbe fare il test per l’HIV, per esempio in Sudafrica, e risultare positivi, e volare in Australia e risultare negativi», ha detto Shenton. All’inizio dell’epidemia di AIDS, molti scienziati ritenevano che fattori legati allo stile di vita, tra cui la dipendenza da droghe ricreative e l’uso di nitriti come i «poppers», fossero la causa dell’AIDS a causa dei danni che provocavano al sistema immunitario. Allo stesso tempo, i funzionari sanitari e i media hanno erroneamente attribuito la diffusione della malattia in Africa all’AIDS, quando in realtà era la mancanza di accesso all’acqua potabile a far ammalare le persone, ha detto Shenton. Queste narrazioni sono cambiate quando le agenzie sanitarie governative hanno iniziato a interessarsi alla ricerca sull’AIDS, ha affermato Shenton. «Quando il CDC [Centers for Disease Control and Prevention] è intervenuto e ha riunito tutti i suoi rappresentanti per esaminare questo gruppo di giovani uomini che erano molto, molto malati… l’intera teoria secondo cui l’AIDS era causato dallo stile di vita o dalla tossicità è scomparsa», ha detto Shenton.Iscriviti al canale Telegram
Fauci ha promosso trattamenti mortali per AIDS e COVID
Shenton ha affermato che i trattamenti medici dannosi sono stati al centro sia dell’epidemia di AIDS che di quella di COVID-19. Nel 1987, la Food and Drug Administration statunitense approvò l’AZT (azidotimidina) per le persone sieropositive. L’AZT si rivelò pericoloso per molti pazienti affetti da AIDS. Durante la pandemia di COVID-19, i vaccini e il remdesivir hanno danneggiato le persone. E in entrambi i casi – l’epidemia di AIDS e la pandemia di COVID-19 – Fauci ha svolto un ruolo chiave. «Eravamo profondamente, profondamente critici nei confronti di Fauci, per il modo in cui ha gestito gli studi multicentrici di fase due sull’AZT. Voglio dire, erano corrotti, e tutta la prima fase è stata finanziata dall’azienda farmaceutica [Burroughs Wellcome, ora GSK ], e avevano dei rappresentanti, e questo è noto attraverso i documenti sulla libertà di informazione, che sono andati lì e hanno portato a casa i risultati del gruppo trattato con il farmaco e del gruppo placebo, eliminando gli effetti collaterali nel gruppo trattato con il farmaco» ha detto la Shenton. Nel film Positively False, diversi scienziati e ricercatori hanno spiegato come l’AZT impedisca la sintesi del DNA, impedisca la replicazione delle cellule e contribuisca alla generazione di cellule cancerose. Tuttavia, secondo il documentario, i pazienti che mettevano in dubbio la sicurezza e l’efficacia dell’AZT venivano stigmatizzati e la loro sanità mentale veniva messa in discussione. Holland ha fatto riferimento al libro del 2021 del Segretario alla Salute degli Stati Uniti Robert F. Kennedy Jr., The Real Anthony Fauci : Bill Gates, Big Pharma, and the Global War on Democracy and Public Health che contiene una sezione sul lavoro di Fauci durante l’epidemia di AIDS. «Solleva tutti questi interrogativi il fatto che in realtà sembra la stessa truffa e gli stessi giocatori… non è cambiato molto», ha detto Holland.Aiuta Renovatio 21
Il «terrore della peste» esisteva molto prima dell’AIDS o del COVID
Secondo Shenton, le epidemie di AIDS e COVID-19 sono esempi di «terrore della peste», che è esistito nel corso della storia. All’inizio del XX secolo, negli Appalachi, fu diagnosticata un’epidemia di pellagra. La malattia, che causava una mortalità diffusa e si diceva fosse infettiva, si rivelò essere una carenza nutrizionale. «Negli Appalachi, la popolazione molto povera viveva con una dieta completamente priva di nutrienti», ha detto Sheton. «Si trattava di una varietà di mais, ma lo cucinavano eliminandone tutti i nutrienti e dipendevano solo da quello». La gente aveva così tanta paura di contrarre la pellagra che coloro che si pensava fossero infetti venivano ricoverati in istituti o «gettati fuori dalle navi», ha affermato. Un infettivologo di New York, il dottor Joseph Goldberger, stabilì che la pellagra non era contagiosa, ma era causata da malnutrizione e carenza di niacina (vitamina B), ha detto Shenton. Fu emarginato per le sue scoperte. «È stato ridotto allo stato laicale, privato dei fondi, ridicolizzato. È morto. E cinque anni dopo la sua morte, hanno detto che aveva assolutamente ragione: non era contagioso, era tossico», ha detto. Secondo Shenton, in Giappone dagli anni ’50 agli anni ’70 la mielo-ottico-neuropatia subacuta (SMON) era comune. «Centinaia di migliaia di giapponesi sono rimasti paralizzati dalla vita in giù e ciechi, e nessuno riusciva a capire il perché. E ovviamente pensavano: “Oh, è un virus”», ha detto. Un neurologo giapponese, il dottor Tadao Tsubaki, ha studiato i pazienti affetti da SMON e ha stabilito che la condizione non era infettiva, ma era causata da un farmaco antidiarroico ampiamente somministrato, il cliochinolo. «Ci sono voluti 30 anni e squadre di avvocati per respingere in tribunale l’idea che la causa della SMON fosse un virus», ha affermato Shenton. Michael Nevradakis Ph.D. © 7 ottobre 2025, Children’s Health Defense, Inc. Questo articolo è riprodotto e distribuito con il permesso di Children’s Health Defense, Inc. Vuoi saperne di più dalla Difesa della salute dei bambini? Iscriviti per ricevere gratuitamente notizie e aggiornamenti da Robert F. Kennedy, Jr. e la Difesa della salute dei bambini. La tua donazione ci aiuterà a supportare gli sforzi di CHD. Renovatio 21 offre questa traduzione per dare una informazione a 360º. Ricordiamo che non tutto ciò che viene pubblicato sul sito di Renovatio 21 corrisponde alle nostre posizioni.Iscriviti alla Newslettera di Renovatio 21
Epidemie
Le restrizioni COVID in Spagna dichiarate incostituzionali, annullate oltre 90.000 multe

Oltre 90.000 multe per violazioni delle norme anti-COVID sono state annullate dopo che la Corte costituzionale spagnola ha dichiarato incostituzionali le severe misure adottate nel 2020.
Secondo il quotidiano spagnuolo The Objective, al 3 settembre 2025 sono state revocate 92.278 sanzioni, in seguito alla sentenza che ha giudicato incostituzionali alcune disposizioni del decreto sullo stato di emergenza del 2020, in vigore durante il primo lockdown per il COVID-19.
Queste sanzioni rappresentano solo la prima tranche di multe destinate all’annullamento, con altre che probabilmente seguiranno. Durante il rigido lockdown del 2020, imposto con lo stato di allarme, sono state emesse oltre 1 milione di sanzioni a livello nazionale, con circa 1,3 milioni di persone multate per aver violato le restrizioni.
La Corte Costituzionale ha stabilito che alcune parti dell’articolo 7 del Regio Decreto 463/2020, relative al divieto generale di circolazione, comportavano una sospensione ingiustificata del diritto fondamentale alla libertà di movimento, andando oltre una semplice limitazione. Tale misura superava i limiti dello stato di allarme, secondo la Corte, che ha precisato che una restrizione così drastica sarebbe stata giustificabile solo con uno stato di emergenza più severo, soggetto a un iter parlamentare più rigoroso.
La sentenza si applica retroattivamente a tutte le multe emesse durante il lockdown del 2020, creando un notevole onere per l’amministrazione statale. The Objective riferisce che «l’applicazione è stata lenta e disuniforme a seconda delle regioni», suggerendo che i rimborsi potrebbero richiedere mesi o anni.
Il quotidiano sottolinea che i 92.278 casi annullati finora rappresentano «solo la punta dell’iceberg di una crisi normativa» derivante dalle severe politiche di lockdown imposte dal governo spagnolo nel 2020.
Iscriviti alla Newslettera di Renovatio 21
Immagine di Javier Perez Montes via Wikimedia pubblicata su licenza Creative Commons Attribution-Share Alike 4.0 International
-
Persecuzioni2 settimane fa
Il ministro israeliano Katz: suore e clero cristiano saranno considerati terroristi se non lasceranno Gaza
-
Immigrazione2 settimane fa
Mons. Viganò: storia delle migrazioni di massa come ingegneria sociale
-
Spirito2 settimane fa
Viganò: «Leone ambisce al ruolo di Presidente del Pantheon ecumenico della Nuova Religione Globale di matrice massonica»
-
Ambiente2 settimane fa
Cringe vaticano ai limiti: papa benedice un pezzo di ghiaccio tra Schwarzenegger e hawaiani a caso
-
Cancro1 settimana fa
Tutti i vaccini contro il COVID aumentano il rischio di cancro, conclude un nuovo studio
-
Civiltà2 settimane fa
«Pragmatismo e realismo, rifiuto della filosofia dei blocchi». Il discorso di Putin a Valdai 2025: «la Russia non mostrerà mai debolezza o indecisione»
-
Salute2 settimane fa
I malori della 40ª settimana 2025
-
Spirito1 settimana fa
Il vescovo Schneider: i cattolici devono adorare Cristo, non l’ideologia LGBT o l’agenda climatica